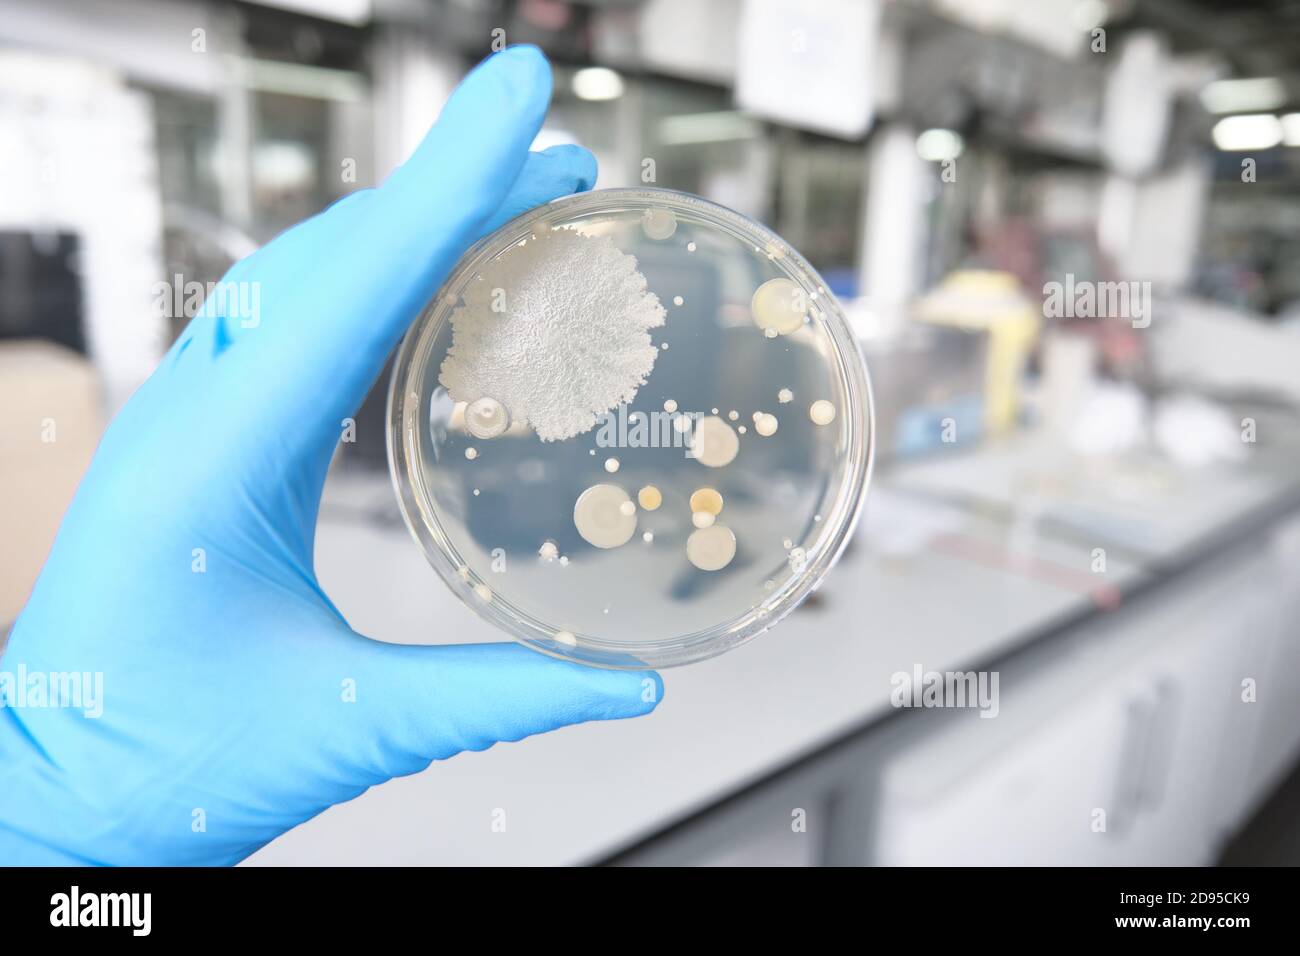

Контроль микробиологической чистоты
Навалом грудились скалы
Улица каховка д 37 к 2
Электродвигатели больших оборотов
Набор для окрашивания одежды тай дай
Что мне стоит тебя забыть
Средство от паразитов в организме человека отзывы
К чему прилипает пыль
Закрытый сын мужа
Elementa eaz
Спорт школа 17
Можно брать бутерброды в самолет ручную кладь
Станция кын
Kp 12 kp ks pt
Контроль микробиологической чистоты 115 фото